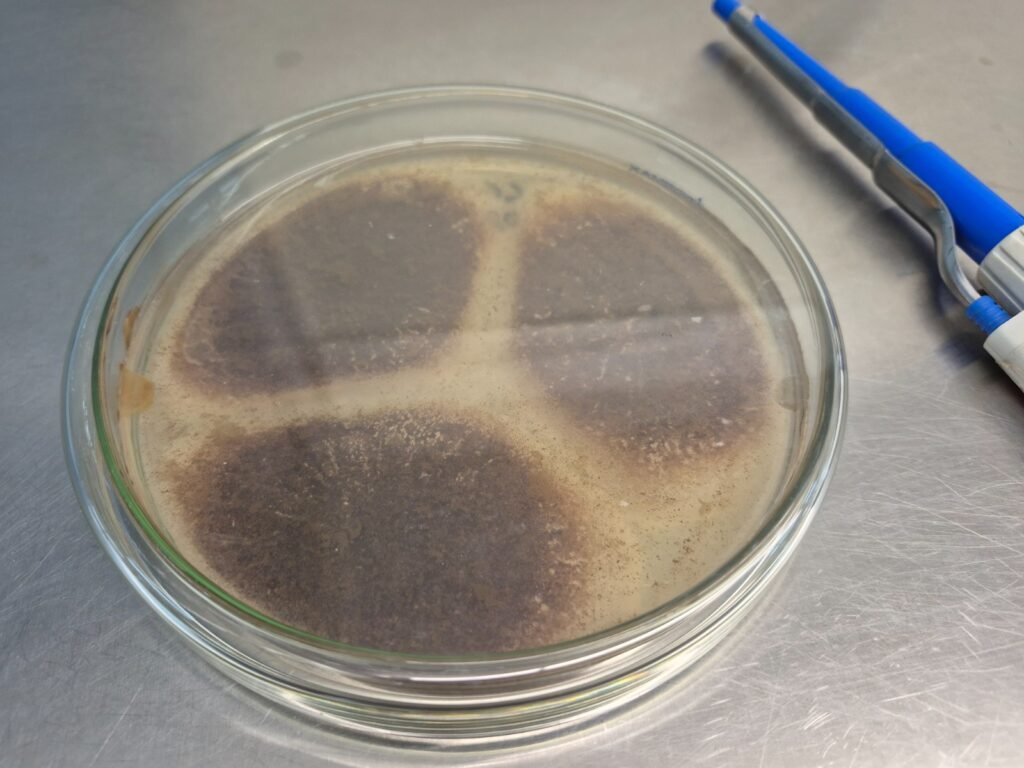
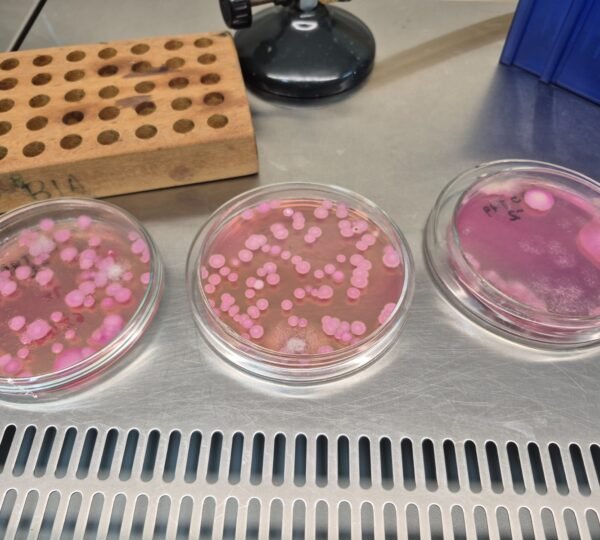

Pesquisa da UFLA testa nova cepa de bactéria como inoculante e observa menor deterioração, redução de perdas e menos risco de micotoxinas — substâncias tóxicas que podem afetar animais e chegar ao leite
Por Simone Paiva – Analista de Comunicação FUNDECC
Uma bactéria isolada de silagens produzidas em Minas Gerais pode se tornar uma aliada importante para quem trabalha com produção de leite e carne. Pesquisadoras da Universidade Federal de Lavras (UFLA – Universidade Federal de Lavras) testaram uma nova cepa de bactéria láctica como inoculante na silagem de milho e observaram resultados animadores: menor deterioração, redução de perdas e menor risco de micotoxinas, compostos tóxicos associados ao crescimento de fungos.
A pesquisa foi financiada pela FAPEMIG – Fundação de Amparo à Pesquisa do Estado de Minas Gerais, com gestão administrativa e financeira da FUNDECC – Fundação de Desenvolvimento Científico e Cultural, fundação de apoio da UFLA.
“A silagem é um alimento conservado por fermentação e fornecido para os animais. Quando o processo não é bem-feito ou quando entra oxigênio em excesso, esse alimento pode se deteriorar”, explica a professora Carla Ávila, engenheira agrônoma, professora e pesquisadora da área de Zootecnia da UFLA.
Silagem, silo e um detalhe que faz toda a diferença: o ar
A silagem é produzida a partir da fermentação de alimentos — neste estudo a planta inteira do milho — e serve para garantir alimento aos animais durante todo o ano, especialmente nos períodos de seca.


Para facilitar o entendimento, a professora resume:
Durante o processo, o alimento é compactado para manter anaerobiose (ausência de oxigênio) e ocorre a fermentação por bactérias lácticas. Estas bactérias porque produzem principalmente o ácido láctico, causando a redução do pH. Esse conjunto de fatores dificulta o crescimento de microrganismos indesejados.
- Silo é o local onde o material é armazenado;
- Silagem é o alimento pronto;
- Ensilagem é o processo de preparo.
O problema começa quando o oxigênio entra — seja por falhas na vedação do silo, seja depois que ele é aberto para a retirada diária do alimento.
Onde mora o risco: fungos, micotoxinas e prejuízo

Quando a silagem entra em contato com o ar, alguns microrganismos encontram condições favoráveis para crescer. Entre eles estão fungos que podem produzir micotoxinas, substâncias tóxicas que afetam a saúde dos animais e podem contaminar produtos de origem animal, como o leite.
“As micotoxinas são problemáticas porque pequenas quantidades já causam efeitos negativos, como queda de imunidade, problemas reprodutivos e redução do consumo de alimento pelos animais”, explica Carla Ávila.
Além do impacto sanitário, a deterioração também pesa no bolso. Parte do alimento se perde ao longo do processo, o que significa menos silagem disponível e maior custo de produção.
O papel dos inoculantes: reforçar o que já é bom
Para reduzir esses riscos, a pesquisa aposta no uso de inoculantes, que são microrganismos adicionados à silagem no momento do preparo para melhorar a fermentação.

No laboratório da UFLA, as pesquisadoras isolam bactérias de silagens, testam seu desempenho e avaliam quais cepas apresentam melhores resultados. Entre as avaliadas neste projeto, uma se destacou: uma cepa da espécie Lentilactobacillus farraginis, isolada de silagens produzidas em Minas Gerais.
Essa cepa foi testada primeiro em condições controladas e, depois, em escala de fazenda, em silos maiores, mais próximos da realidade do produtor rural.
Menos perdas e silagens mais estáveis
Nos experimentos, a silagem inoculada apresentou menor crescimento de leveduras, microrganismos que costumam iniciar o processo de deterioração quando o silo é aberto. Com isso, a silagem se manteve mais estável ao contato com o ar, preservando melhor seu valor nutricional.
Outro ponto importante foi a redução das perdas de matéria seca, ou seja, menos alimento “desapareceu” ao longo do processo de fermentação e uso.
“Quando o produtor perde menos silagem, ele aproveita melhor o que produziu. Isso impacta diretamente o custo e a eficiência do sistema”, destaca a pesquisadora.
Micotoxinas: um resultado que chama atenção

A equipe também analisou a presença de micotoxinas, uma etapa complexa e de alto custo. De acordo com os resultados relatados, a silagem inoculada apresentou menor concentração da micotoxina detectada, em comparação à silagem sem inoculante, ao longo do tempo de fermentação.
Além de evitar o aumento, o inoculante deu indícios de contribuir para reduzir a concentração dessa substância, um efeito que já é discutido na literatura científica.
“Isso indica que essas bactérias podem ter algum papel na redução ou detoxificação das micotoxinas”, disse a professora.
Ganho para o produtor, para os animais e para quem consome
Os benefícios se espalham em cadeia. Para o produtor, menos perdas significam mais alimento disponível e menor prejuízo. Para os animais, uma silagem mais estável e segura melhora a qualidade da dieta. Para o consumidor, a redução do risco de micotoxinas contribui para a segurança dos alimentos de origem animal.
Há ainda um reflexo ambiental: ao reduzir perdas, o produtor pode produzir a mesma quantidade de alimento utilizando menos área plantada, o que também dialoga com sustentabilidade.
Ciência que pode virar tecnologia
O grupo de pesquisa já acumula experiência em transferência de tecnologia, quando resultados científicos se transformam em soluções aplicadas no campo. A nova cepa segue em fase final de validação, com estudos avançados e acordos em andamento para futuras etapas. “É gratificante ver um trabalho de anos no laboratório se transformar em algo que pode chegar ao produtor”, resume a professora.
A visão de quem está em formação

A pesquisa também envolve estudantes de pós-graduação. A doutoranda Yasmin Alvarenga Silva, do Departamento de Zootecnia da UFLA, acompanha estudos semelhantes e destaca a importância prática do trabalho.
“O principal é conseguir gerar tecnologias que ajudem a conservar melhor a silagem e reduzir as perdas, que ainda são um problema comum no campo”, afirma.
Deixe um comentário